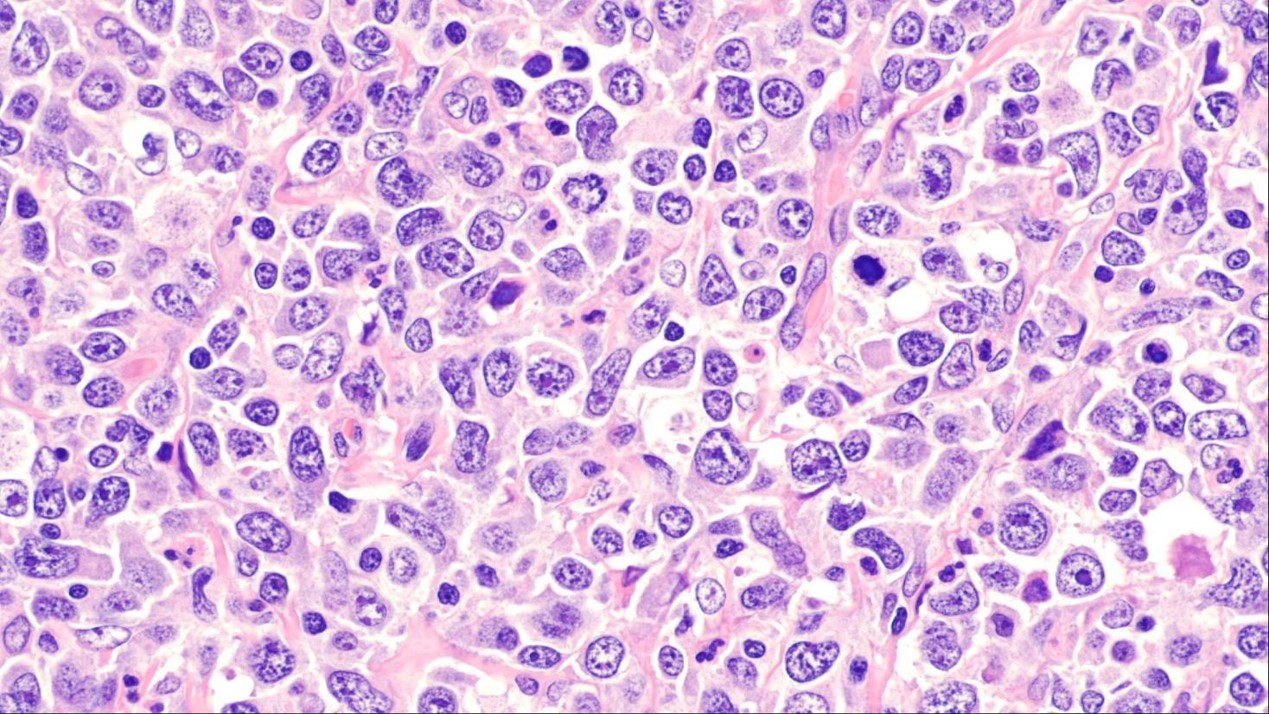
Microscope image of human cells coloured different shades of pink, purple and white.

Researchers at the University of Southampton have identified a new subtype of lymphoma which could pave the way to improved and more targeted treatments for some blood cancer patients.
The cancer scientists and biologists have also found that lymphoma cells of this new subtype carry a unique sugar that promotes the survival and growth of the cancer.
Lymphoma is a type of blood cancer that affects white blood cells called lymphocytes. There are many different types of lymphoma, but this latest breakthrough is in a type called diffuse large B-cell lymphoma (DLBCL), which affects our B cells. When operating normally, B cells help to fight infection in the body.
Within DLBCL, the researchers have now discovered a new subtype named 'Mann-type DLBCL'.
The team, who worked with researchers in Canada and the United States, have described their findings in a recently published paper in the journal Blood .
Lead researcher Professor Francesco Forconi of the University of Southampton's Cancer B-cell Group says: "Patients with this new subtype, Mann-type DLBCL, have a high-risk cancer that cannot respond well to conventional therapies, so identifying this as a distinct group is very important to their treatment programme.
"Understanding the type of cancers we fight is a crucial part of battling the disease and opens the door to developing new and improved therapies."
The scientists analysed data from 595 DLBCL patients, accessed through two separate cohort datasets of DLBCL from the BC Cancer Agency (BCCA) de-novo DLBCL cohort and the National Cancer Institute (NCI) DLBCL. They looked for a specific sugar called mannose on the key B-cell receptor and successfully identified it in around a third of all DLBCL.
The researchers found that Mann-type DLBCL lymphoma cells always carry this sugar and are not sensitive to conventional anti-cancer drugs. Mannose is found naturally on the surface of many infective agents like viruses, but is typically not abundant on normal human cells.
.jpg)
The sugar's presence helps the cancer cells to survive and grow more quickly, making them resistant to standard treatments - eventually resulting in an aggressive form of cancer and poorer outcomes for patients.
Director of the University of Southampton's Institute for Life Sciences and co-author of the paper, Professor Max Crispin , comments: "It is highly unusual to see these kinds of carbohydrates play such a defining role in cancer biology. Finding mannose structures driving tumour growth is remarkable and a powerful example of how interdisciplinary science, combining molecular insight with clinical data, can transform our understanding of disease."
This research to identify Mann-type DLBCL means doctors can now recognise specific cases of this type more easily using conventional laboratory tests. The breakthrough means the scientists can now work to find more effective, tailored treatments for this subtype and help provide better patient outcomes.






